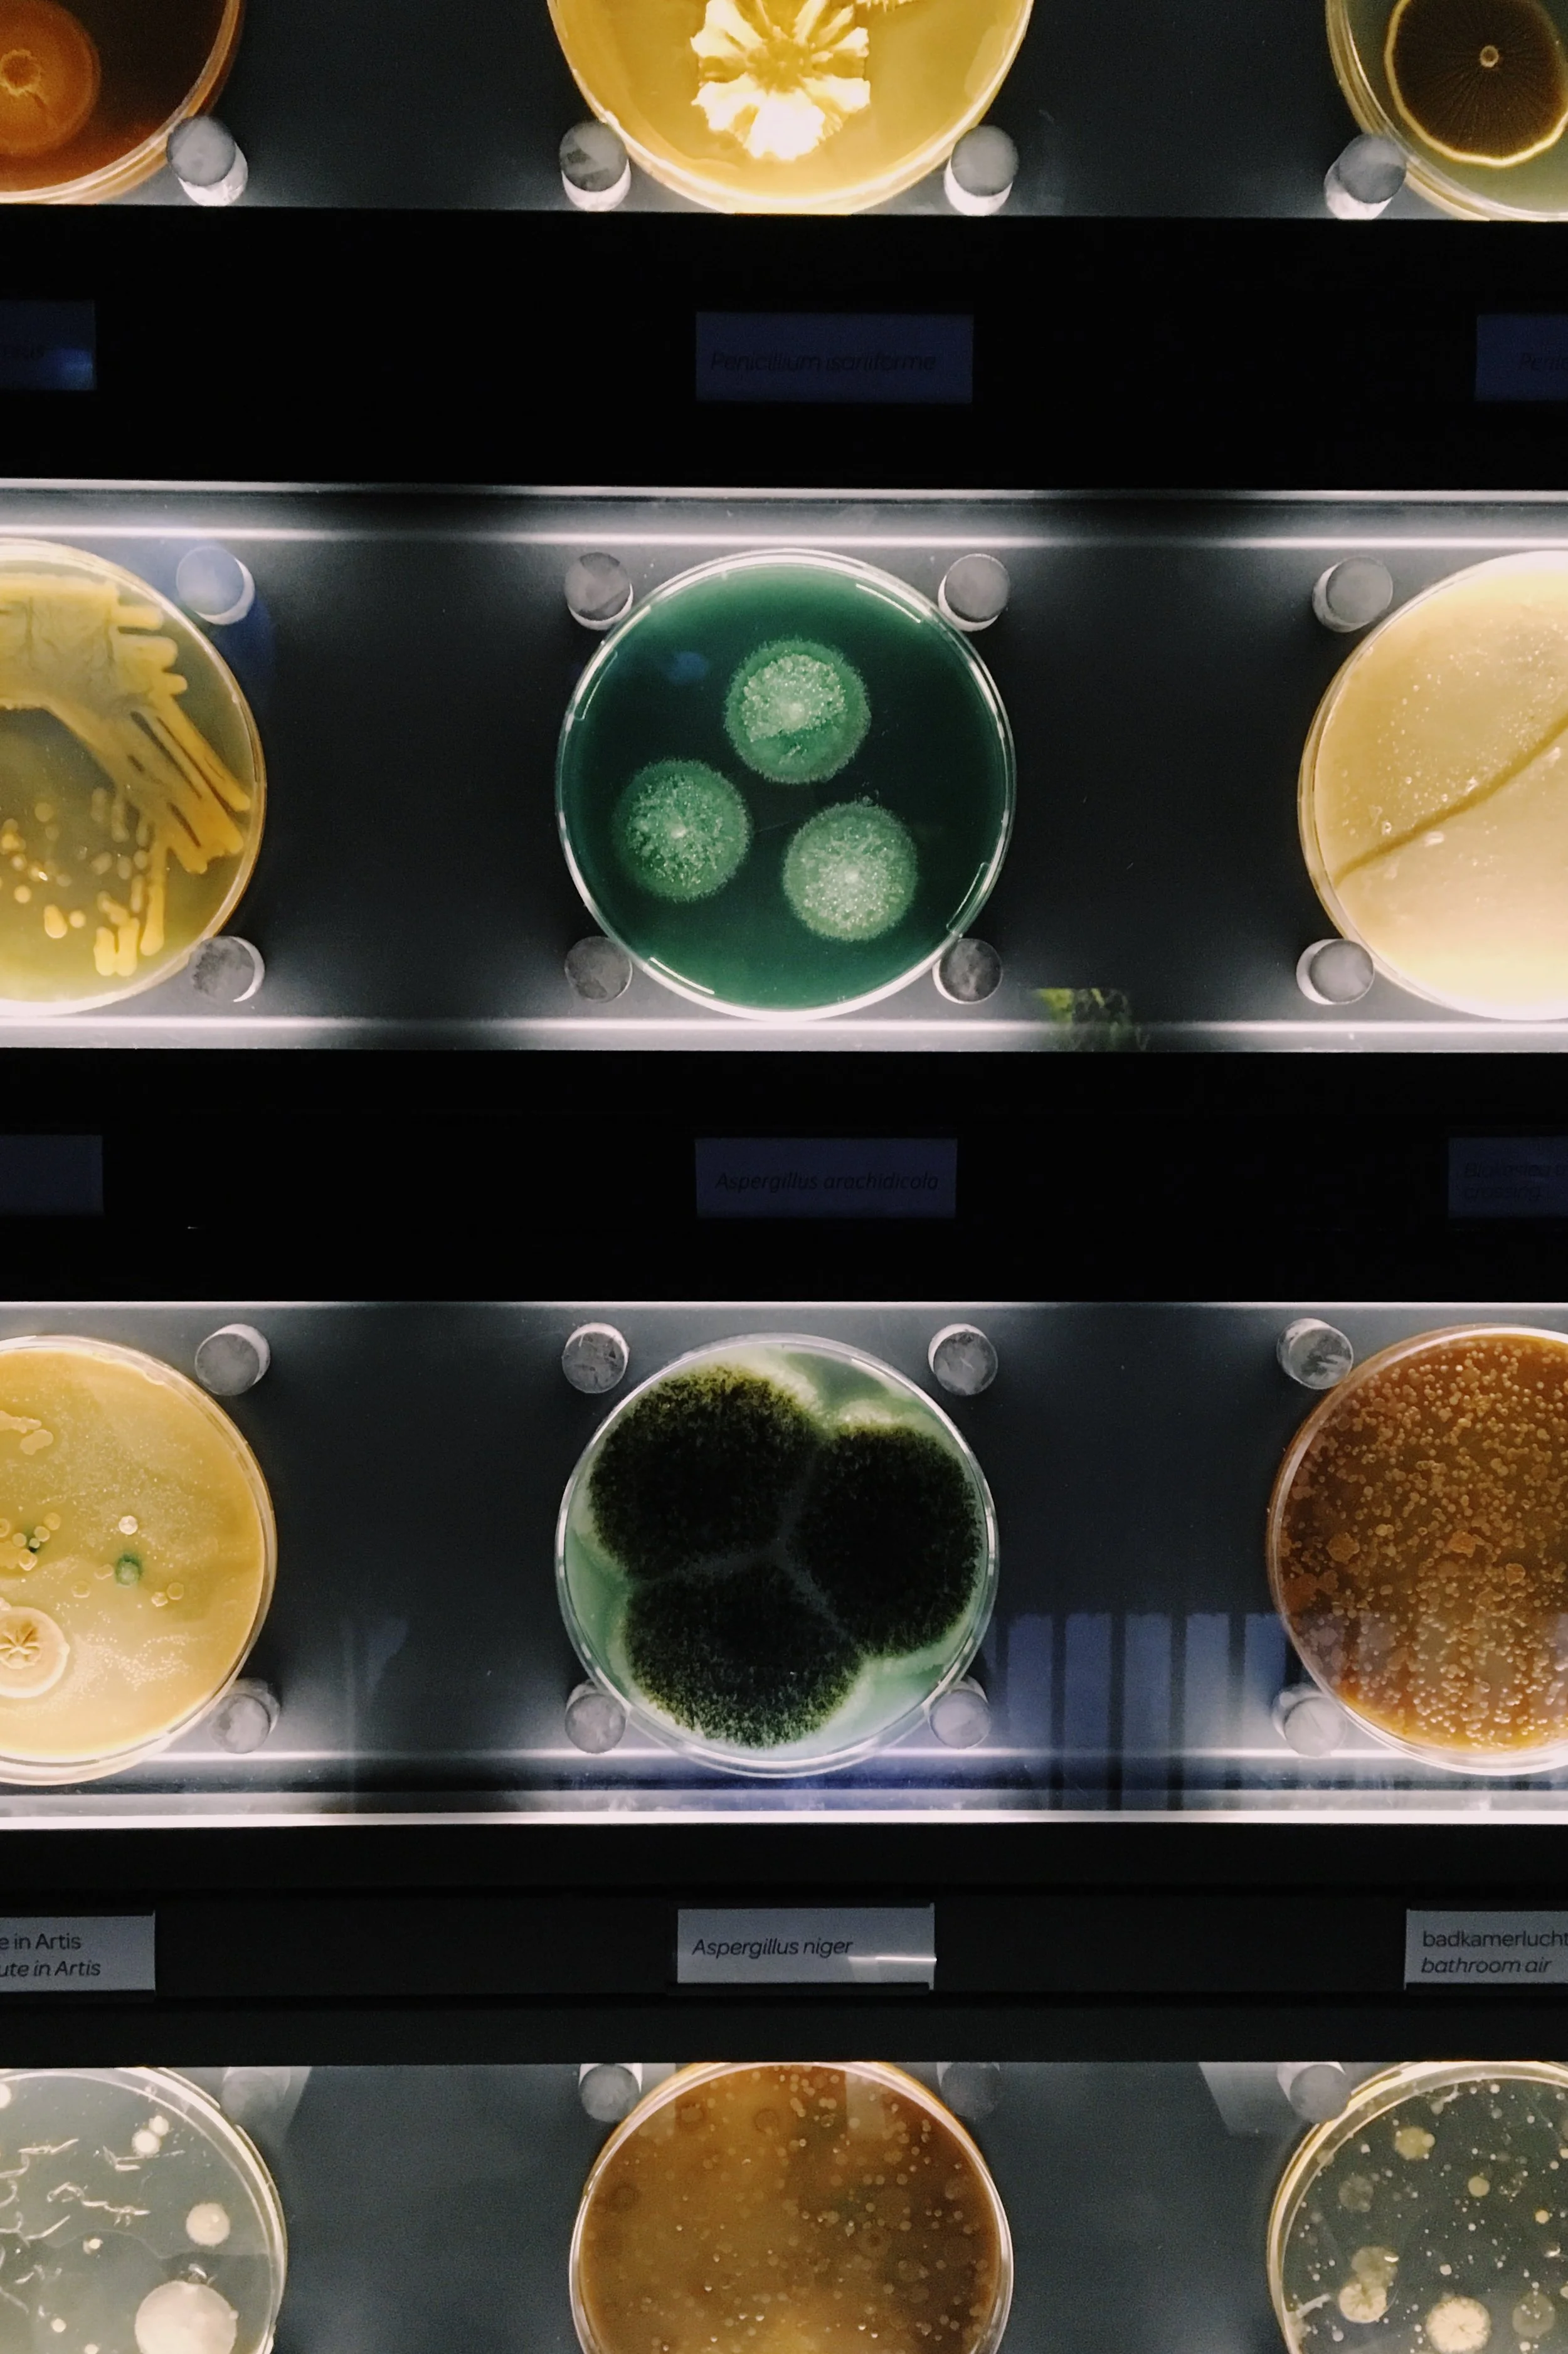

Micropia, Amsterdam
Sorry if microbes aren’t your thing but to me, they are endlessly fascinating. Sadly I don’t do microbiology anymore and tend to focus on bigger organisms and systems so this museum was hella fun to explore. I only had my iphone on me so not many snaps. Highlights included the tardigrades (water bears), bacteria under the microscope and live experiments going on with walls of petri dishes and shelves of decaying food. If they are you thing then I recommend 10% Human by Alanna Collen